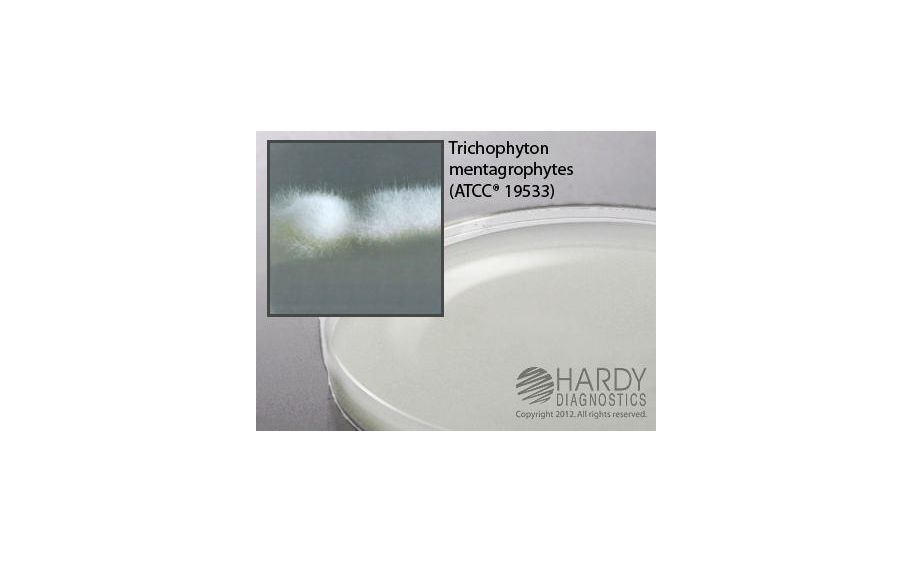
main product photo

Need Help?
800-229-7252

AGAR POTATO FLAKE SELECTIVE 15X100MM PLT
1
/
PK
Lead Time
12 Day(s)
SKU
VWR75814-672-PK
MFRPN
W159
AGAR POTATO FLAKE SELECTIVE 15X100MM PLT
Potato Flake Selective Agar (with Ciprofloxacin and Vancomycin) deep fill Potato Flake Selective Agar (with Ciprofloxacin and Vancomycin) deep fill, 15x100mm plate, For the selective isolation of pathogenic fungi.
| Manufacturer | Hardy Diagnostics |
|---|---|
| MFRPN | W159 |
| Lead Time | 12 Day(s) |
| UNSPSC Code | 12000000 |
Write Your Own Review